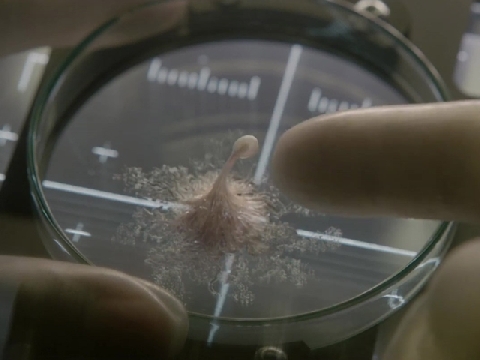

Bạn chưa đăng nhập! Vui lòng Đăng nhập để xem được nội dung.
Cận cảnh Scarlett Johansson khỏa thân trong 'Vỏ Bọc Ma'
03/04/2017 | 4.6K Lượt xem
'Ghost in the Shell' (Vỏ Bọc Ma) là phim hành động, khoa học viễn tưởng chuyển thể từ truyện tranh cùng tên của Nhật. Trong phim, kiều nữ Scarlett Johansson hóa thân thành một robot sinh học có cơ thể cấu tạo từ máy móc trừ bộ não và xương sống. Trong trích đoạn mới nhất, khán giả được chứng kiến cảnh 'khỏa thân' của Scarlett Johansson. Từ chiếc hồ chứa dung dịch trắng đục, nhân vật trồi lên, sau đó lớp vỏ bọc như kén tằm bên ngoài vỡ ra phô bày thân thể bằng máy của cô.

{{(count_comment == 0)?('Bình luận'):(count_comment+' Bình luận')}}
Những bình luận hàng đầu
{{comment.username}}
{{comment.content}}
{{item.username}}
{{item.content}}